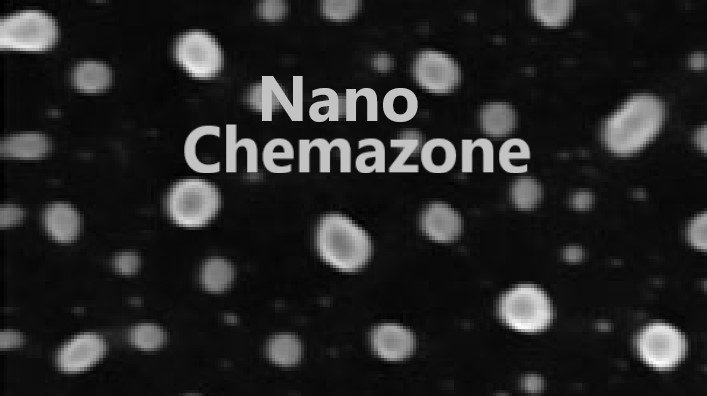

Copper Silver Alloy Nanopowder
$0.00
| MF: | Cu:Ag |
| Chemical Name: |
Copper Silver Alloy Nanoparticles |
| Purity: | > 99.99% |
| APS: | <100nm (Size Customization possible) |
| Form: | Nanopowder |
| Product Number: | NCZA111 |
| CAS Number: | 11144-43-7 |
Size Options: also available in the micro size range and 325 Mesh, 200 Mesh, etc. (Ask for the customization)
Category: Alloy Powder
Description
Note: For pricing & ordering information, please contact us at sales@nanochemazone.com
Please contact us for quotes on Larger Quantities & Customization. E-mail: contact@nanochemazone.com
Customization:
If you are planning to order large quantities for your industrial and academic needs, please note that customization of parameters (such as size, length, purity, functionalities etc.) are available upon request.
Shipping & Delivery
Related products
Aluminium Alloy Nanopowder
$0.00
Aluminium Nickel Alloy Nanopowder
$0.00
| MF: | Al:Ni |
| Chemical Name: |
Aluminium Nickel Alloy Powder |
| Purity: | > 99.99% |
| APS: | APS 70 nm, APS 10 µm, APS 40-50 µm (Size Customization possible) |
| Form: | Nanopowder and Micropowder |
| Product Number: | NCZA104 |
| CAS Number: | 12635-27-7 / 12635-29-9 |
Copper Nickel Alloy Nanopowder
$0.00
Copper Nickel Alloy Nanopowder
Copper Nickel (Cu: Ni) Alloy Nanoparticles
| MF: | Cu:Ni |
| Chemical Name: | Copper Nickel Alloy Nanopowder |
| Purity: | > 99.99% |
| APS: | <100 nm (Size Customization possible) |
| Form: | Nanopowder |
| Product Number: | NCZA109 |
| CAS Number: | 7440-50-8 / 7440-02-0 |
Copper Tin Alloy Nanopowder
$0.00
Devarda Alloy Powder
$0.00
| MF: | Al:Cu:Zn |
| Chemical Name: |
Devarda Alloy Powder |
| Purity: | > 99.9% |
| APS: | 80-100 nm (Size Customization possible) |
| Form: | Nanopowder |
| Product Number: | NCZA114 |
| CAS Number: | 8049-11-4 |
Iron Chromium Cobalt Magnet Nanopowder
$0.00
| MF: | Fe:Cr:Co |
| Chemical Name: | Iron Chromium Cobalt Magnet Nanopowder |
| Purity: | > 99.99% |
| APS: | <80 nm (Size Customization possible) |
| Form: | Nanopowder |
| Product Number: | NCZA117 |
| CAS Number: | 7439-89-6 / 7440-47-3 / 7440-48-4 |
Manganese Zinc Alloy Nanopowder
$0.00
| MF: | Mn:Zn |
| Chemical Name: |
Manganese Zinc Alloy Nanopowder |
| Purity: | > 99.99% |
| APS: | <80 nm (Size Customization possible) |
| Form: | Nanopowder |
| Product Number: | NCZA124 |
| CAS Number: | 7439-96-5 / 7440-66-6 |
Palladium Silver Alloy Nanopowder
$0.00